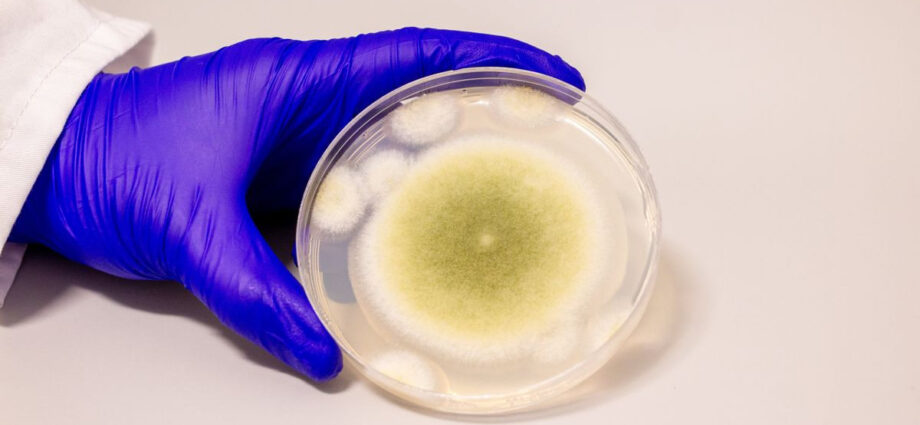

(Πηγή: www.techgear.gr)
Ένας μύκητας που συνδέθηκε ιστορικά με θανάσιμες λοιμώξεις και μυστηριώδεις θανάτους εξερευνητών αρχαίων τάφων φαίνεται σήμερα να κρύβει θεραπευτικές δυνατότητες ενάντια σε μια από τις πιο επιθετικές μορφές καρκίνου. Νέα επιστημονική έρευνα αναδεικνύει ότι ο Aspergillus flavus, ο τοξικός μύκητας που ενοχοποιήθηκε για τους θανάτους μετά το άνοιγμα του τάφου του Τουταγχαμών, ενδέχεται να αποτελέσει τη βάση για καινοτόμες θεραπείες κατά της λευχαιμίας.
Η σύνδεση του μύκητα με τον θρύλο της «κατάρας των Φαραώ» δεν είναι τυχαία. Το 1922, λίγους μήνες μετά την ανακάλυψη του τάφου του βασιλιά Τουταγχαμών στην Αίγυπτο, ο Άγγλος λόρδος που είχε χρηματοδοτήσει την ανασκαφή και επισκέφθηκε… Πηγή